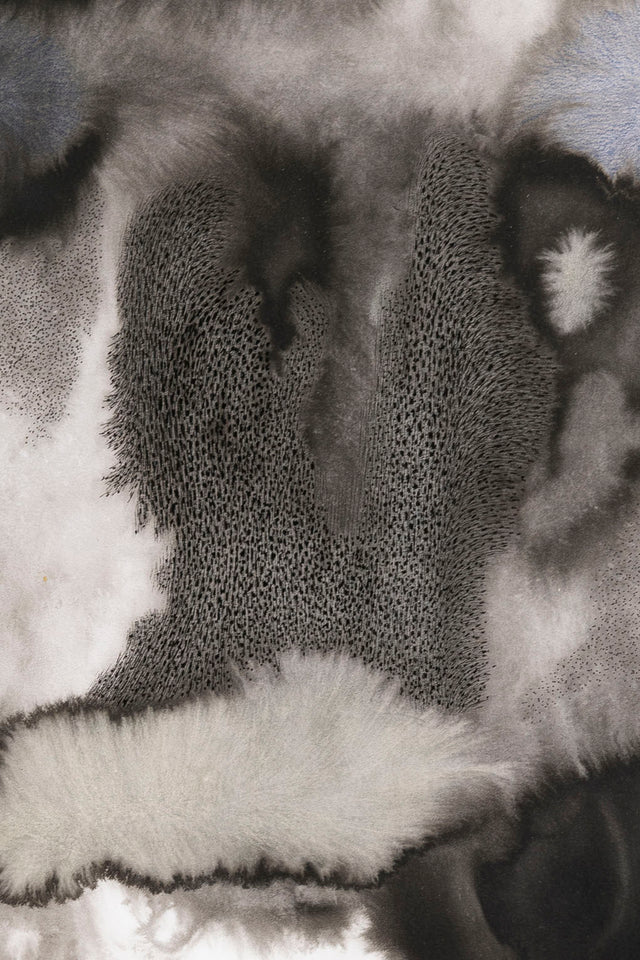

AQUA 1
Specifications
Ink, markers
Dimensions
39 x 39 CM
Edition
Unique piece
Year
2024


x
Request price